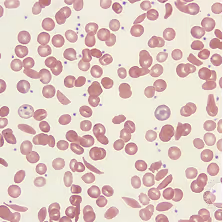

When the genome becomes a language, you can understand it.
Our specialized genomic foundation model turns years of trial-and-error into weeks of predictive, therapeutic-grade gene editing design, ensuring the next life-saving therapy is ready in time.
Backed by investors from:
Backed by investors from:
Our Story
We know what’s possible. Now let’s make it scalable.
In early 2025, a bespoke CRISPR therapy saved Baby KJ. It looked fast; in truth it stood on multi-year, multi-team trial-and-error and international collaboration. The next leap is making that speed reproducible.

2012
CRISPR revolution begins
Jennifer Doudna, Emmanuelle Charpentier, and collaborators reveal CRISPR-Cas9 as a programmable tool to cut DNA at precise sites sparking a global revolution in biology and medicine.

2016
First in vivo genome editing trial
Sangamo demonstrates permanent DNA editing in humans using Zinc-Finger Nucleases (ZFNs) for Hunter syndrome
2023
First CRISPR therapy (CASGEVY™ by Vertex Pharmaceuticals) approved
The first CRISPR-based therapy is approved for sickle-cell disease and beta-thalassemia. To date, it remains the only genome editing therapy on the market.

2024
cassidy bio is founded
Created with the purpose of making genome editing medicines scalable, predictable and accessible.

2025
baby kj treated
Baby KJ receives the first personalized, in vivo CRISPR base-editing therapy; designed and delivered in just months to correct his rare mutation.

Looking forward
A decade that delivers not one, but hundreds of approved gene therapies engineered with intelligence, validated and deployed at scale.

I’ve been fortunate to witness gene editing’s journey from its earliest days to its first clinical breakthroughs. What’s clear now is that the future depends on rapid, systematic and reliable design. That requires teams capable of uniting computational intelligence with biological expertise.
Vic Myer, PhD, former CTO at Editas, former CSO at Chroma Medicine, Advisor at Cassidy Bio
What Cassidy does
We are the intelligence layer for gene editing.
A genomic foundation model built to engineer genome editing systems: from guides to editors, and delivery contexts.
Proprietary wet-lab datasets in therapeutic conditions — high-throughput assays and NGS validation — create the biological foundation that powers and improves the model.
A genomic foundation model tuned on 70,000 genetically diverse human genomes, embedding population-aware safety and contextual knowledge into the system.
End-to-end in silico prediction across efficacy, safety, repair outcomes, and genomic diversity shortlisting the most promising outcomes.
Experimental results feed back into the system, closing the loop between intelligence and biology to continuously strengthen predictive power.

The promise of genome editing will only be realized when we move beyond isolated successes and build a foundation that can scale. Clinical confidence at the very first step is essential if we are to unlock the true scale of this field and deliver therapies to the millions upon millions of patients who stand to benefit.
Rom Kshuk, CEO of Cassidy Bio
Applications
Choose outcomes with clinical confidence. Cassidy makes that decision simple.
Cassidy empowers partners to move faster and smarter in therapeutic gene editing. Our platform shortlists the best candidates across gRNA design, enzyme selection, and genomic variation, cutting years of trial-and-error down to days.

Select patient-fit guides and editors across variant backgrounds

Match editing systems and their contexts appropriately to cell-types

Plan multiplex edits with predicted repair outcomes
our team
Scientists, engineers, and builders of the CRISPR era
Our team spans AI pioneers who built foundation models and scientists who shaped the CRISPR era. Together, we bridge in silico, wet lab, and clinical development, united by a vision to make gene editing reliable, scalable, and transformative for patients.

CEO
Rom Kshuk
Serial biotech entrepreneur; scaled Future Meat Technologies, raising $400M with over 100 employees.

CSO
Ayal Hendel, PhD
Ayal Hendel earned his PhD in biochemistry from the Weizmann Institute of Science and completed postdoctoral research at Stanford University, where he contributed to early innovations in CRISPR-based genome editing.

CTO
Yaniv Shmueli, PhD
AI pioneer; co-author of Meta’s foundational ESM protein design model.

Head of Genomics
Dane Hazelbaker, PhD
Genomics leader; former Tome Biosciences director and Broad Institute scientist.

Head of Biology
Yael Yoffe Mizrahi, PhD
NK cell therapy expert; led biology programs at Gamida Cell and trained at Weizmann Institute.

Head of Bioinformatics
Ilona Kifer, PhD

Head of AI and Engineering
Noam Barkai
Advisors
Doron Lipson, PhD
Genomics strategist; Former CSO of Ultima Genomics
Daniel O’Connell, PhD
Bioinformatics veteran; ex-VP Genomics at Tome, former Intellia Therapeutics director.
Scientific Advisory Board
Saar I. Gill, MD, PhD
Physician-scientist; UPenn professor advancing hematology-oncology with translational CRISPR insights.
Vic Myer, PhD
CTO at Editas and CSO at Chroma Medicine; seasoned executive with deep experience bringing gene editing from concept to clinic.
Advisors
Doron Lipson, PhD
Genomics strategist; Former CSO of Ultima Genomics
Daniel O’Connell, PhD
Bioinformatics veteran; ex-VP Genomics at Tome, former Intellia Therapeutics director.
Scientific Advisory Board
Saar I. Gill, MD, PhD
Physician-scientist; UPenn professor advancing hematology-oncology with translational CRISPR insights.
Vic Myer, PhD
CTO at Editas and CSO at Chroma Medicine; seasoned executive with deep experience bringing gene editing from concept to clinic.